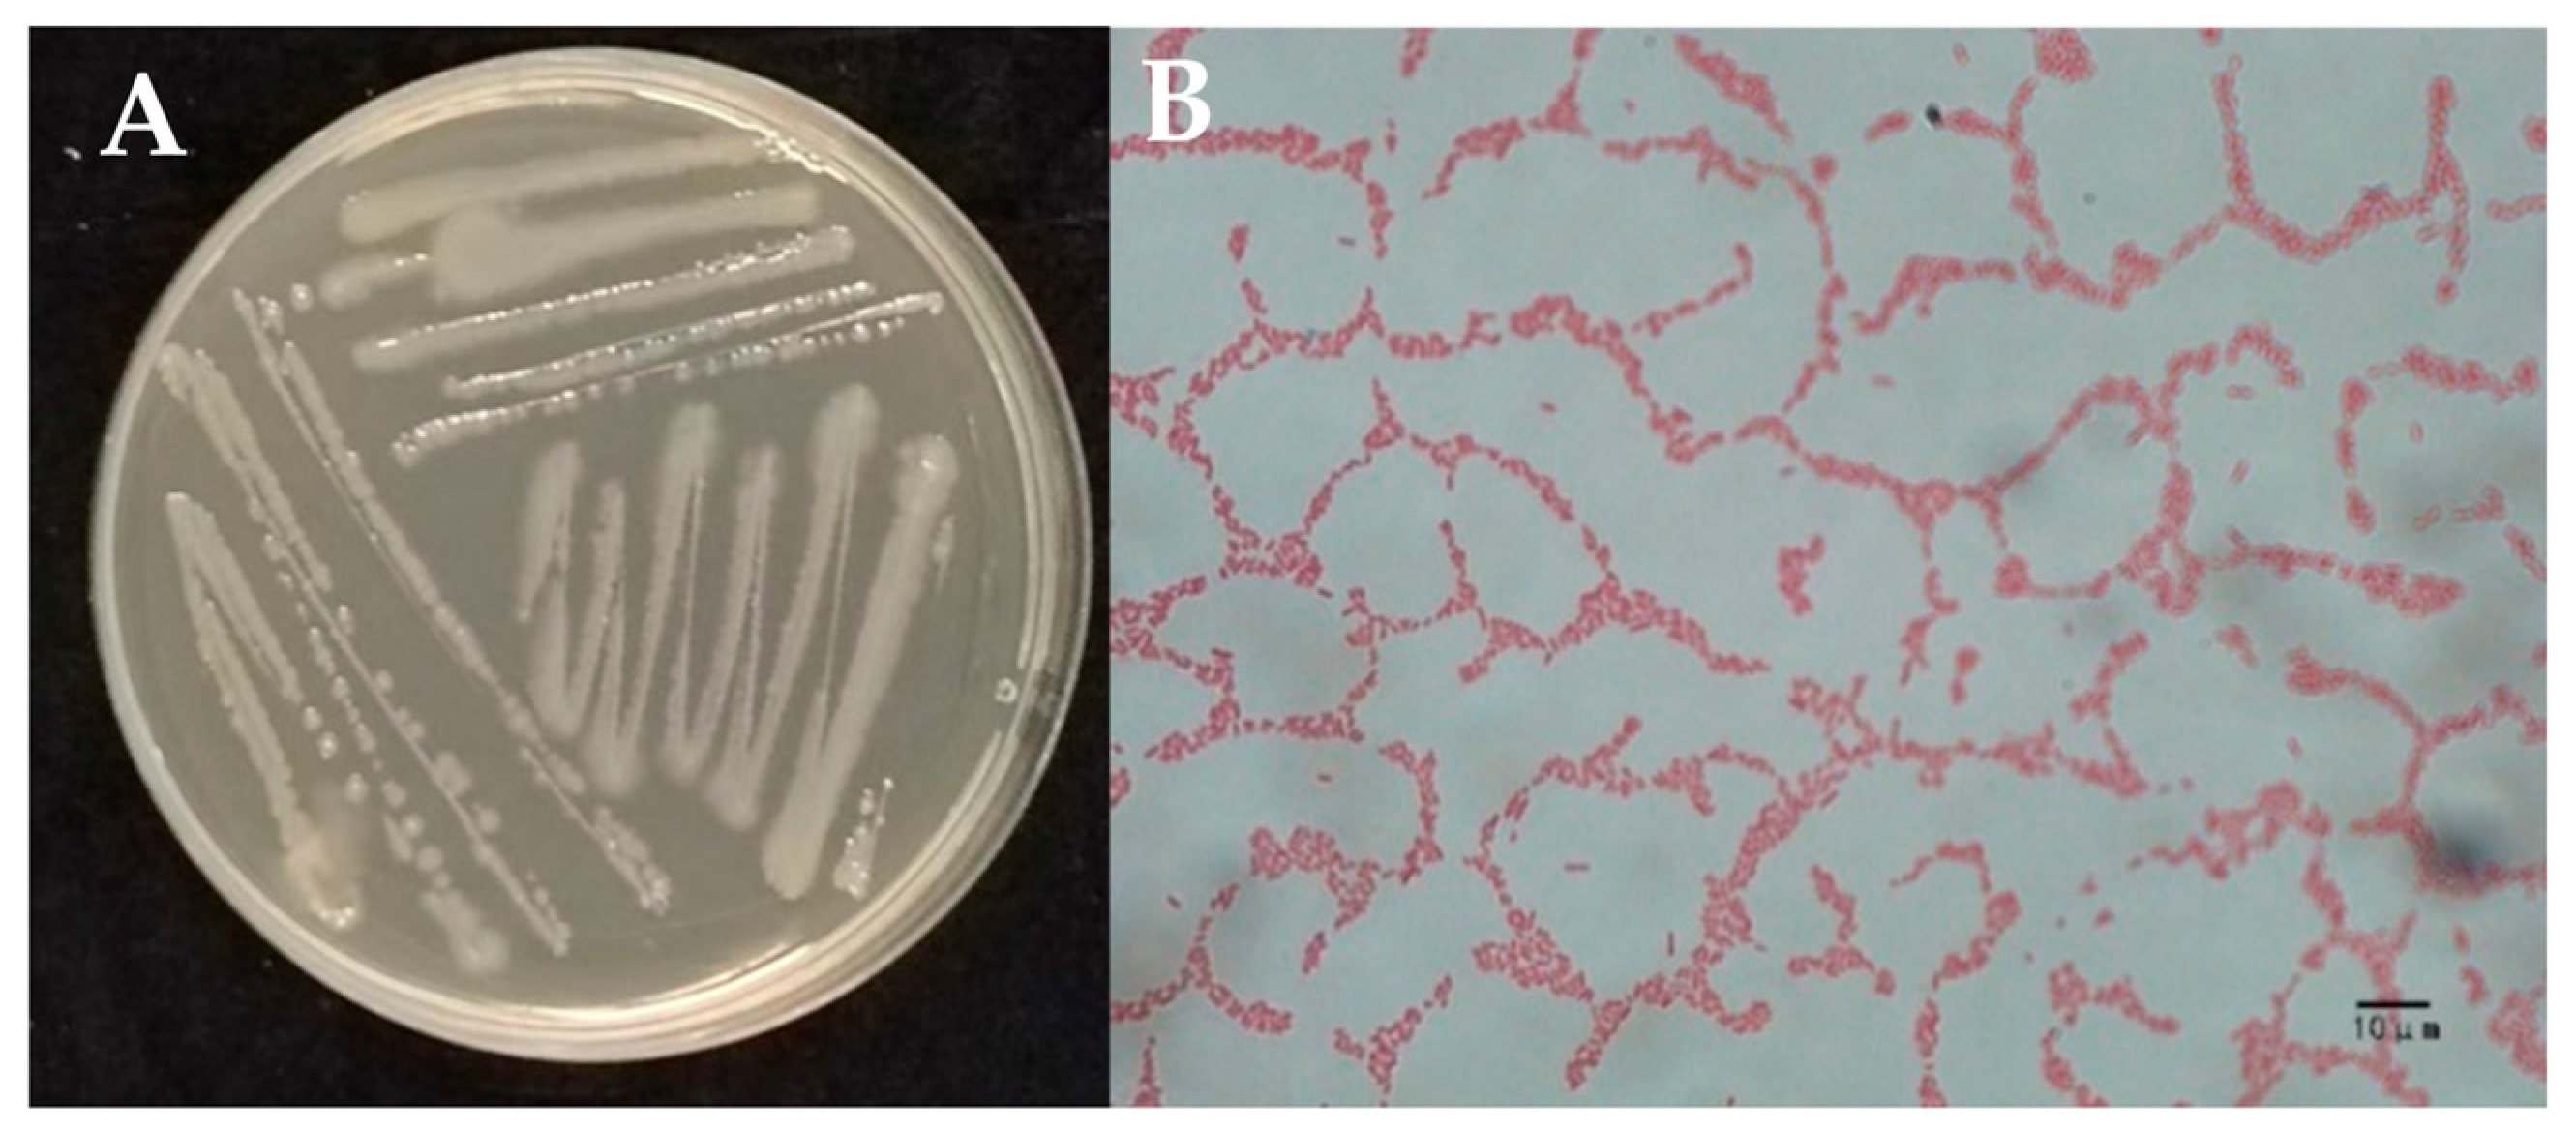
Ijms 26 03335 g002

Integrated Management of Bacterial Wilt and Root-Knot Nematode Diseases in Pepper: Discovery of Phenazine-1-Carboxamide from Pseudomonas aeruginosa W-126
Abstract
:1. Introduction
2. Results
2.1. Antibacterial Results of Endophytic Bacteria Against R. solanacearum
2.2. Identification of Strain W-126
2.3. Isolation and Extraction of Bacteriostatic Substances from Strain W-126
2.4. Inhibitory Effect on R. solanacearum and Identification of Compound W-s1
2.5. Antibacterial Activity of PCN Against Phytopathogenic Bacteria and M. incognita
2.6. Results of Activity of PCN Analogues Against R. solanacearum and M. incognita
2.7. Pot Experiment Results of PCN for Controlling Complex Diseases of R. solanacearum and M. incognita
3. Discussion
4. Materials and Methods
4.1. Bacterial Cultures and Nematode Inoculum
Plant Materials and Test Strains
4.2. Antibacterial Activity Determination of Endophytic Bacteria Against R. solanacearum
4.2.1. Preparation of R. solanacearum Suspension
4.2.2. Antibacterial Activity Determined by the Filter Paper Diffusion Method
4.3. Identification of Strain W-126
4.4. Isolation and Extraction of Bacteriostatic Substances from Strain W-126
4.4.1. Crude Extraction and Its Bacteriostatic Activity Determination
4.4.2. Isolation of Bacteriostatic Substances from Strain W-126 Crude Extraction
4.5. Identification of Bacteriostatic Compound from Strain W-126
4.6. Antibacterial Determination of PCN Against 6 Phytopathogenic Bacteria and M. incognita
4.7. Activity Determination of PCN Analogues Against R. solanacearum and M. incognita
4.8. Pot Experiment on PCN for Controlling Complex Diseases of R. solanacearum and M. incognita
4.9. Statistical Analysis
5. Conclusions
Supplementary Materials
Author Contributions
Funding
Institutional Review Board Statement
Informed Consent Statement
Data Availability Statement
Acknowledgments
Conflicts of Interest
References
- Yaseen, I.; Mukhtar, T.; Mubarik, A.; Arshad, B.; Sahu, N.; Somaddar, U. Management of Ralstonia solanacearum-Meloidogyne incognita complex with Trichoderma harzianum in tomato. Bragantia 2024, 84, e20240060. [Google Scholar]
- Sharmila, V.; Gnanaraj, M.; Sundar, M.B.; Alodaini, H.A.; Ahamed, A.; Jebastin, T. Functional annotation of hypothetical proteins from Ralstonia solanacearum UW551, a bacterium that causes wilt disease, uncovers proteins involved in virulence and pathogenicity. J. Plant Dis. Prot. 2025, 132, 46. [Google Scholar] [CrossRef]
- Zhao, Q.; Cao, J.; Cai, X.; Wang, J.; Kong, F.; Wang, D.; Wang, J. Antagonistic activity of volatile organic compounds produced by acid-tolerant Pseudomonas protegens CLP-6 as biological fumigants to control tobacco bacterial wilt caused by Ralstonia solanacearum. Appl. Environ. Microbiol. 2023, 89, e0189222. [Google Scholar] [CrossRef]
- Parrado, L.M.; Quintanilla, M. Plant-parasitic nematode disease complexes as overlooked challenges to crop production. Front. Plant Sci. 2024, 15, 1439951. [Google Scholar] [CrossRef]
- Bhat, A.A.; Shakeel, A.; Waqar, S.; Handoo, Z.A.; Khan, A.A. Microbes vs. nematodes: Insights into biocontrol through antagonistic organisms to control root-knot nematodes. Plants 2023, 12, 451. [Google Scholar] [CrossRef]
- Getu, T.; Mohammed, W.; Seid, A.; Mekete, T.; Kassa, B. Evaluation of the reaction of various potato (Solanum tuberosum L.) cultivars to the Meloidogyne incognita and Ralstonia solanacearum disease complex under field conditions. Potato Res. 2024, 67, 73–91. [Google Scholar] [CrossRef]
- Furusawa, A.; Uehara, T.; Ikeda, K.; Sakai, H.; Tateishi, Y.; Sakai, M.; Nakaho, K. Ralstonia solanacearum colonization of tomato roots infected by Meloidogyne incognita. J. Phytopathol. 2019, 167, 338–343. [Google Scholar] [CrossRef]
- Archana, T.S.; Kumar, D.; Kumar, V.; Shukuru, B.N. Root-knot disease complex: An interactive perspective with microorganisms. In Root-Galling Disease of Vegetable Plants; Springer Nature: Singapore, 2023; pp. 237–251. [Google Scholar]
- Siddiqui, Z.A.; Nesha, R.; Singh, N.; Alam, S. Interactions of plant-parasitic nematodes and plant-pathogenic bacteria. In Bacteria in Agrobiology: Plant Probiotics; Springer: Berlin/Heidelberg, Germany, 2012; pp. 251–267. [Google Scholar] [CrossRef]
- Khan, M.; Siddiqui, A.Z. Effect of simultaneous and sequential inoculations of Meloidogyne incognita, Ralstonia solanacearum and Phomopsis vexans on eggplant in sand mix and fly ash mix soil. Phytoparasitica 2017, 45, 599–609. [Google Scholar] [CrossRef]
- Uehara, T.; Nakaho, K. Effects of high grafting on tomato plants infected by Meloidogyne incognita and Ralstonia solanacearum. J. Phytopathol. 2018, 166, 53–58. [Google Scholar] [CrossRef]
- Amorim, D.J.; Tsujimoto, T.F.; Baldo, F.B.; Leite, L.G.; Harakava, R.; Wilcken, S.R.S.; Gabia, A.A. Bacillus, Pseudomonas and Serratia control Meloidogyne incognita (Rhabditida: Meloidogynidae) and promote the growth of tomato plants. Rhizosphere 2024, 31, 100935. [Google Scholar] [CrossRef]
- Siddiqui, Z.A.; Khan, M.R.; Aziz, S. Use of manganese oxide nanoparticle (MnO2 NPs) and Pseudomonas putida for the management of wilt disease complex of carrot. Exp. Parasitol. 2024, 257, 108698. [Google Scholar] [CrossRef] [PubMed]
- Yang, X.; Yu, H.; Ren, J.; Cai, L.; Xu, L.; Liu, L. Sulfoxide-containing bisabolane sesquiterpenoids with antimicrobial and nematicidal activities from the marine-derived fungus Aspergillus sydowii LW09. J. Fungi 2023, 9, 347. [Google Scholar] [CrossRef] [PubMed]
- Shehata, A.S.; Samy, M.A.; Sobhy, S.E.; Farag, A.M.; El-Sherbiny, I.M.; Saleh, A.A.; Hafez, E.E.; Abdel-Mogib, M.; Aboul-Ela, H.M. Isolation and identification of antifungal, antibacterial and nematocide agents from marine bacillus gottheilii MSB1. BMC Biotechnol. 2024, 24, 92. [Google Scholar] [CrossRef] [PubMed]
- Chaudhary, P.; Agri, U.; Chaudhary, A.; Kumar, A.; Kumar, G. Endophytes and their potential in biotic stress management and crop production. Front. Microbiol. 2022, 13, 933017. [Google Scholar] [CrossRef]
- Ogbe, A.A.; Finnie, J.F.; Van Staden, J. The role of endophytes in secondary metabolites accumulation in medicinal plants under abiotic stress. South Afr. J. Bot. 2020, 134, 126–134. [Google Scholar] [CrossRef]
- Pandey, P.; Tripathi, A.; Dwivedi, S.; Lal, K.; Jhang, T. Deciphering the mechanisms, hormonal signaling, and potential applications of endophytic microbes to mediate stress tolerance in medicinal plants. Front. Plant Sci. 2023, 14, 1250020. [Google Scholar] [CrossRef]
- de Medeiros Silva, R.; de Castro Lima, M.M.; Cotinguiba, F. Dereplication of 4-Quinolone alkaloids from Waltheria Indica (Malvaceae) tissues using molecular network tools. Chem. Biodivers. 2024, 21, e202400665. [Google Scholar] [CrossRef]
- Liu, F.; O’donnell, T.J.; Park, E.-J.; Kovacs, S.; Nakamura, K.; Dave, A.; Luo, Y.; Sun, R.; Wall, M.; Wongwiwatthananukit, S.; et al. Anti-inflammatory quinoline alkaloids from the roots of Waltheria indica. J. Nat. Prod. 2023, 86, 276–289. [Google Scholar] [CrossRef]
- Yin, F.; Liu, Q.; Zhang, B.; Zhang, X.; He, J.; Xie, J.; Hu, Z.; Sun, R. Microemulsion preparation of Waltheria indica extracts and preliminary antifungal mechanism exploration. Ind. Crops Prod. 2021, 172, 114000. [Google Scholar] [CrossRef]
- Durairaj, K.; Velmurugan, P.; Park, J.-H.; Chang, W.-S.; Park, Y.-J.; Senthilkumar, P.; Choi, K.-M.; Lee, J.-H.; Oh, B.-T. Potential for plant biocontrol activity of isolated Pseudomonas aeruginosa and Bacillus stratosphericus strains against bacterial pathogens acting through both induced plant resistance and direct antagonism. FEMS Microbiol. Lett. 2017, 364, fnx225. [Google Scholar] [CrossRef]
- Elazouni, I.; Abdel-Aziz, S.; Rabea, A. Microbial efficacy as biological agents for potato enrichment as well as bio-controls against wilt disease caused by Ralstonia solanacearum. World J. Microbiol. Biotechnol. 2019, 35, 30. [Google Scholar] [CrossRef]
- Ma, L.; Zhang, H.-Y.; Zhou, X.-K.; Yang, C.-G.; Zheng, S.-C.; Duo, J.-L.; Mo, M.-H. Biological control tobacco bacterial wilt and black shank and root colonization by bio-organic fertilizer containing bacterium Pseudomonas aeruginosa NXHG29. Appl. Soil Ecol. 2018, 129, 136–144. [Google Scholar] [CrossRef]
- Camacho, M.; Santos, B.d.L.; Vela, M.D.; Talavera, M. Use of bacteria isolated from berry rhizospheres as biocontrol agents for charcoal rot and root-knot nematode strawberry diseases. Horticulturae 2023, 9, 346. [Google Scholar] [CrossRef]
- Poria, V.; Jhilta, P.; Adhuna, K.P.; Somvanshi, V.S.; Rana, A.; Singh, S. Multistress-tolerant Pseudomonas aeruginosa SSVP3 uses multiple strategies to control Meloidogyne incognita in tomato. Plant Pathol. 2024, 73, 2395–2407. [Google Scholar] [CrossRef]
- Ge, X.; Wei, W.; Li, G.; Sun, M.; Li, H.; Wu, J.; Hu, F. Isolated Pseudomonas aeruginosa strain VIH2 and antagonistic properties against Ralstonia solanacearum. Microb. Pathog. 2017, 111, 519–526. [Google Scholar] [CrossRef]
- Jayanna, S.K.; Umesha, S. Quorum quenching activity of rhizosphere bacteria against Ralstonia solanacearum. Rhizosphere 2017, 4, 22–24. [Google Scholar] [CrossRef]
- Shanmugaiah, V.; Mathivanan, N.; Varghese, B. Purification, crystal structure and antimicrobial activity of phenazine-1-carboxamide produced by a growth-promoting biocontrol bacterium, Pseudomonas aeruginosa MML2212. J. Appl. Microbiol. 2010, 108, 703–711. [Google Scholar] [CrossRef]
- Zhou, L.; Jiang, H.; Jin, K.; Sun, S.; Zhang, W.; Zhang, X.; He, Y.-W. Isolation, identification and characterization of rice rhizobacterium Pseudomonas aeruginosa PA1201 producing high level of biopesticide” Shenqinmycin” and phenazine-1-carboxamide. Wei Sheng Wu Xue Bao Acta Microbiol. Sin. 2015, 55, 401–411. [Google Scholar] [PubMed]
- Zhang, Y.; Wang, C.; Su, P.; Liao, X.L.; Liu, S.Q. Anti-phytopathogens activity of antibiotic compound F125 (Phenazine-1-carboxamide) from a Pseudomonas aeruginosa strain SU8. Egypt. J. Biol. Pest Control. 2016, 26, 387. [Google Scholar]
- Kanugala, S.; Jinka, S.; Puvvada, N.; Banerjee, R.; Kumar, C.G. Phenazine-1-carboxamide functionalized mesoporous silica nanoparticles as antimicrobial coatings on silicone urethral catheters. Sci. Rep. 2019, 9, 6198. [Google Scholar] [CrossRef]
- Liu, H.-X.; Li, S.-M.; Luo, Y.-M.; Luo, L.-X.; Li, J.-Q.; Guo, J.-H. Biological control of Ralstonia wilt, Phytophthora blight, Meloidogyne root-knot on bell pepper by the combination of Bacillus subtilis AR12, Bacillus subtilis SM21 and Chryseobacterium sp. R89. Eur. J. Plant Pathol. 2014, 139, 107–116. [Google Scholar] [CrossRef]
- Olajuyigbe, O.O.; Babalola, A.E.; Afolayan, A.J. Antibacterial and phytochemical screening of crude ethanolic extracts of Waltheria indica Linn. Afr. J. Microbiol. Res. 2011, 5, 3760–3764. [Google Scholar] [CrossRef]
- Liang, C.; Yang, L.; Shao, Y.; Zhu, X.; Zhao, H.; Chen, B.; Song, W.; Song, X.; Ding, X.; Sun, R. Broad-spectrum antifungal activity of dichloromethane extract of Waltheria indica stems and isolated compounds. Ind. Crops Prod. 2019, 142, 111855. [Google Scholar] [CrossRef]
- Jang, J.Y.; Le Dang, Q.; Choi, G.J.; Park, H.W.; Kim, J. Control of root-knot nematodes using Waltheria indica producing 4-quinolone alkaloids. Pest Manag. Sci. 2019, 75, 2264–2270. [Google Scholar] [CrossRef]
- Nirmala, C.; Sridevi, M. Characterization, antimicrobial and antioxidant evaluation of biofabricated silver nanoparticles from Endophytic Pantoea anthophila. . Inorg. Organomet. Polym. Mater. 2021, 31, 3711–3725. [Google Scholar] [CrossRef]
- Zheng, X.; Qin, Z.; Kang, J.; Wan, C.; Li, G.; Wang, X. An active compound from Pseudomonas aeruginosa B27. Nat. Prod. Commun. 2022, 17, 1934578X221086897. [Google Scholar] [CrossRef]
- Meena, H.; Siddhardha, B. Acyl homoserine lactone regulated quorum sensing in plant co-habitating microorganisms and their agricultural significance. In Microbes in Agri-Forestry Biotechnology; CRC Press: Boca Raton, FL, USA, 2022; pp. 369–390. [Google Scholar]
- Krishnaiah, M.; Rodriguez de Almeida, N.; Udumula, V.; Song, Z.; Chhonker, Y.S.; Abdelmoaty, M.M.; Aragao do Nascimento, V.; Murry, D.J.; Conda-Sheridan, M. Synthesis, biological evaluation, and metabolic stability of phenazine derivatives as antibacterial agents. Eur. J. Med. Chem. 2018, 143, 936–947. [Google Scholar] [CrossRef]
- Peterson, N.D.; Tse, S.Y.; Huang, Q.J.; Wani, K.A.; Schiffer, C.A.; Pukkila-Worley, R. Non-canonical pattern recognition of a pathogen-derived metabolite by a nuclear hormone receptor identifies virulent bacteria in C. elegans. Immunity 2023, 56, 768–782.e9. [Google Scholar] [CrossRef]
- Qi, Z.; Liu, F.; Li, D.; Yin, J.; Wang, D.; Ahmed, N.; Ma, Y.; Zhou, J.-J.; Chen, Z. Phenazine-1-carboxamide regulates pyruvate dehydrogenase of phytopathogenic fungi to control tea leaf spot caused by Didymella segeticola. Phytopathology 2025, 115, 139–150. [Google Scholar] [CrossRef]
- Chen, Y.; Wang, J.; Yang, N.; Wen, Z.; Sun, X.; Chai, Y.; Ma, Z. Wheat microbiome bacteria can reduce virulence of a plant pathogenic fungus by altering histone acetylation. Nat. Commun. 2018, 9, 3429. [Google Scholar] [CrossRef]
- Li, L.; Ran, T.; Zhu, H.; Yin, M.; Yu, W.; Zou, J.; Li, L.; Ye, Y.; Sun, H.; Wang, W.; et al. Molecular mechanism of Fusarium fungus inhibition by phenazine-1-carboxamide. J. Agric. Food Chem. 2024, 72, 15176–15189. [Google Scholar] [CrossRef] [PubMed]
- Manu, P.; Nketia, P.B.; Osei-Poku, P.; Kwarteng, A. Computational mutagenesis and inhibition of Staphylococcus aureus AgrA LytTR domain using phenazine scaffolds: Insight from a biophysical study. BioMed Res. Int. 2024, 2024, 8843954. [Google Scholar] [CrossRef] [PubMed]
- Ma, Q.; Zhong, Y.; Huang, P.; Li, A.; Jiang, T.; Jiang, L.; Yang, H.; Wang, Z.; Wu, G.; Huang, X.; et al. Bioactive naphthoquinone and phenazine analogs from the endophytic Streptomyces sp. PH9030 as α-Glucosidase Inhibitors. Molecules 2024, 29, 3450. [Google Scholar] [CrossRef] [PubMed]
- Minini, L.; Álvarez, G.; González, M.; Cerecetto, H.; Merlino, A. Molecular docking and molecular dynamics simulation studies of Trypanosoma cruzi triosephosphate isomerase inhibitors. Insights into the inhibition mechanism and selectivity. J. Mol. Graph. Model. 2015, 58, 40–49. [Google Scholar] [CrossRef]
- He, D.; Gao, C.; Zhao, S.; Chen, H.; Li, P.; Yang, X.; Li, D.; Zhao, T.; Jiang, H.; Liu, C. Antibacterial, herbicidal, and plant growth-promoting properties of Streptomyces sp. STD57 from the rhizosphere of Adenophora stricta. Microorganisms 2024, 12, 2245. [Google Scholar] [CrossRef]
- Yan, L.; Li, G.; Liang, Y.; Tan, M.; Fang, J.; Peng, J.; Li, K. Co-production of surfactin and fengycin by Bacillus subtilis BBW1542 isolated from marine sediment: A promising biocontrol agent against foodborne pathogens. J. Food Sci. Technol. 2024, 61, 563–572. [Google Scholar] [CrossRef]
- Fan, X.; Kong, D.; He, S.; Chen, J.; Jiang, Y.; Ma, Z.; Feng, J.; Yan, H. Phenanthrene derivatives from Asarum heterotropoides showed excellent antibacterial activity against phytopathogenic bacteria. J. Agric. Food Chem. 2021, 69, 14520–14529. [Google Scholar] [CrossRef]
- Mao, G.; Tian, Y.; Shi, J.; Liao, C.; Huang, W.; Wu, Y.; Wen, Z.; Yu, L.; Zhu, X.; Li, J. Design, synthesis, antibacterial, and antifungal evaluation of phenylthiazole derivatives containing a 1, 3, 4-thiadiazole thione moiety. Molecules 2024, 29, 285. [Google Scholar] [CrossRef]
- Zhang, X.; Hu, Z.; Wang, S.; Yin, F.; Wei, Y.; Xie, J.; Sun, R. Discovery of 2-aphthol from the leaves of Actephila merrilliana as a natural nematicide candidate. J. Agric. Food Chem. 2023, 71, 13209–13219. [Google Scholar] [CrossRef]
- Yu, G.; Chen, S.; Guo, S.; Xu, B.; Wu, J. Trifluoromethylpyridine 1, 3, 4-oxadiazole derivatives: Emerging scaffolds as bacterial agents. ACS Omega 2021, 6, 31093–31098. [Google Scholar] [CrossRef]
- Gattoni, K.M.; Park, S.W.; Lawrence, K.S. Evaluation of the mechanism of action of Bacillus spp. to manage Meloidogyne incognita with split root assay, RT-qPCR and qPCR. Front. Plant Sci. 2023, 13, 1079109. [Google Scholar] [CrossRef] [PubMed]
- Rabbee, M.F.; Hwang, B.S.; Baek, K.H. Bacillus velezensis: A beneficial biocontrol agent or facultative phytopathogen for sustainable agriculture. Agronomy 2023, 13, 840. [Google Scholar] [CrossRef]
- Ambarwati, E.; Arwiyanto, T.; Widada, J.; Alam, T.; Andika, I.P. The genes associated with jasmonic acid and salicylic acid are induced in tropical chili pepper against Ralstonia solanacearum by applying arbuscular mycorrhizal fungi. Horticulturae 2022, 8, 876. [Google Scholar] [CrossRef]

| Pathogenic Bacteria | Regression Equation | R2 | EC50 (µg/mL) | Inhibition Rate (%) at 250 µg/mL |
|---|---|---|---|---|
| X. oryzae pv. oryzae | Y = −4.17 + 1.86x | 0.915 | 184.10 | 54.25 ± 0.39 |
| X. manihotis | Y = −12.59 + 4.95x | 0.997 | 361.71 | 31.53 ± 0.75 |
| P. syringae | Y = −8.35 + 3.39x | 0.999 | 286.56 | 45.23 ± 0.53 |
| X. oryzae pv. oryzicola | Y = −5.35 + 2.06x | 0.989 | 387.29 | 40.86 ± 1.03 |
| X. campestris | Y = −8.4 + 3.93x | 0.991 | 138.70 | 71.46 ± 0.12 |
| R. solanacearum | Y = −4.76 + 2.66x | 0.950 | 64.16 | 87.88 ± 0.99 |
| M. incognita | Y = −9.57 + 4.63x | 0.975 | 118.63 | 83.68 ± 2.17 |
| Number | Compounds | CAS | Inhibitory Rate (%) | |
|---|---|---|---|---|
| R. solanacearum | M. incognita | |||
| 1 | Phenazin-1-ylamine | 2876-22-4 | −7.63 ± 1.70 | 66.86 ± 1.50 |
| 2 | 3-Amino-phenazin-2-ol | 4569-77-1 | 63.41 ± 0.75 | 25.58 ± 0.89 |
| 3 | 1-Methoxyphenazine | 2876-17-7 | −19.85 ± 4.42 | 34.29 ± 1.58 |
| 4 | PCN | 550-89-0 | 68.18 ± 2.15 | 54.62 ± 2.29 |
| 5 | Phenazine | 92-82-0 | 66.33 ± 5.81 | 52.52 ± 1.92 |
| 6 | 1-Hydroxyphenazine | 528-71-2 | 33.34 ± 1.37 | 62.67 ± 1.97 |
| 7 | Dipyrido [3,2-a:2′,3′-c]phenazine | 19535-47-8 | 9.12 ± 1.92 | 23.65 ± 2.12 |
| 8 | Phenazine-1-carboxylic acid | 2538-68-3 | 21.02 ± 1.61 | 12.41 ± 1.34 |
| 9 | Safranine T | 477-73-6 | −34.17 ± 7.16 | 28.57 ± 0.74 |
| 10 | Phenazine methosulfate | 299-11-6 | 82.77 ± 4.73 | 16.67 ± 0.58 |
| 11 | Neutral Red | 553-24-2 | 67.00 ± 1.07 | 9.67 ± 0.58 |
| 12 | 2,3-Diaminophenazine | 655-86-7 | −24.48 ± 6.9 | 19.66 ± 2.05 |
| 13 | Azocarmine G | 25641-18-3 | −25.89 ± 2.67 | 6.97 ± 0.64 |
| 14 | Methylene Violet 3RAX | 4569-86-2 | 30.02 ± 7.77 | 27.40 ± 0.81 |
| 15 | Phenazine ethosulfate | 10510-77-7 | 37.06 ± 2.10 | 8.56 ± 0.63 |
| 16 | 1,6-Phenazinediol | 69-48-7 | 44.04 ± 2.07 | 15.25 ± 0.79 |
| 17 | Phenazine 5,10-dioxide | 303-83-3 | 14.55 ± 0.80 | 22.00 ± 0.91 |
| 18 | Abamectin | 71751-41-2 | - | 100 |
| 19 | Streptomycin sulfate | 3810-74-0 | 98.91 ± 1.48 | - |
| Treatment | Plant Height (cm) | Plant Weight (g) | M. incognita | R. solanacearum | ||
|---|---|---|---|---|---|---|
| Root-Knot Number | Control Efficiency (%) | Disease Index | Control Efficiency (%) | |||
| CK- | 35.09 ± 2.16a | 2.80 ± 0.12a | - | - | - | - |
| CK | 34.26 ± 1.84a | 2.22 ± 0.15b | 68.67 ± 1.53a | - | 73.52 ± 3.83a | - |
| PCN | 34.00 ± 2.76a | 2.38 ± 0.19b | 41.33 ± 0.58b | 39.80 ± 0.90c | 35.80 ± 4.28d | 51.41 ± 3.35a |
| Zhuorun | 34.03 ± 2.83a | 2.38 ± 0.10b | 27.33 ± 1.15d | 60.16 ± 2.41a | 50.62 ± 4.28c | 30.58 ± 1.74b |
| W-126 | 33.75 ± 1.83a | 2.36 ± 0.09b | 31.33 ± 2.08c | 54.31 ± 3.96b | 45.68 ± 4.28c | 37.57 ± 8.76b |
| Streptomycin sulfate | 34.50 ± 2.93a | 2.35 ± 0.06bc | 66.67 ± 1.53a | 2.92 ± 0.07d | 30.86 ± 4.27d | 57.76 ± 7.74a |
| Abamectin | 32.38 ± 3.58a | 2.34 ± 0.07bc | 23.33 ± 2.08e | 65.99 ± 3.45a | 65.43 ± 4.28b | 11.04 ± 1.82c |
Disclaimer/Publisher’s Note: The statements, opinions and data contained in all publications are solely those of the individual author(s) and contributor(s) and not of MDPI and/or the editor(s). MDPI and/or the editor(s) disclaim responsibility for any injury to people or property resulting from any ideas, methods, instructions or products referred to in the content. |
© 2025 by the authors. Licensee MDPI, Basel, Switzerland. This article is an open access article distributed under the terms and conditions of the Creative Commons Attribution (CC BY) license (https://creativecommons.org/licenses/by/4.0/).
Share and Cite
Wang, S.; Wang, Y.; Yao, Y.; Li, W.; Hu, Z.; Li, D.; Sun, R. Integrated Management of Bacterial Wilt and Root-Knot Nematode Diseases in Pepper: Discovery of Phenazine-1-Carboxamide from Pseudomonas aeruginosa W-126. Int. J. Mol. Sci. 2025, 26, 3335. https://doi.org/10.3390/ijms26073335
Wang S, Wang Y, Yao Y, Li W, Hu Z, Li D, Sun R. Integrated Management of Bacterial Wilt and Root-Knot Nematode Diseases in Pepper: Discovery of Phenazine-1-Carboxamide from Pseudomonas aeruginosa W-126. International Journal of Molecular Sciences. 2025; 26(7):3335. https://doi.org/10.3390/ijms26073335
Chicago/Turabian StyleWang, Shuai, Yifan Wang, Youzhi Yao, Wenzhuo Li, Zhan Hu, Dong Li, and Ranfeng Sun. 2025. "Integrated Management of Bacterial Wilt and Root-Knot Nematode Diseases in Pepper: Discovery of Phenazine-1-Carboxamide from Pseudomonas aeruginosa W-126" International Journal of Molecular Sciences 26, no. 7: 3335. https://doi.org/10.3390/ijms26073335
APA StyleWang, S., Wang, Y., Yao, Y., Li, W., Hu, Z., Li, D., & Sun, R. (2025). Integrated Management of Bacterial Wilt and Root-Knot Nematode Diseases in Pepper: Discovery of Phenazine-1-Carboxamide from Pseudomonas aeruginosa W-126. International Journal of Molecular Sciences, 26(7), 3335. https://doi.org/10.3390/ijms26073335







